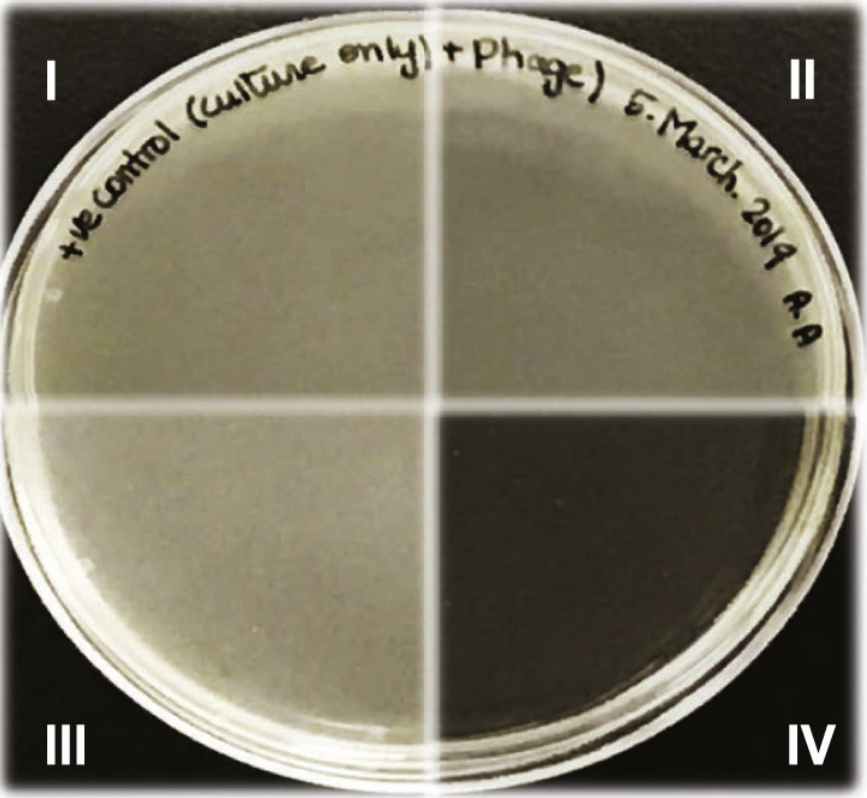
Published Paper!

Hiba dropped by to say hello (and goodbye!), something we didn’t really get to do after her defence! And, as her flights are booked for her PhD in Ireland starting later this month, I’ll raise a parting glass. Good night, and joy be with you all!
It’s been a while since we’ve welcomed brand new members to the team - so it’s with particular delight that I get to welcome our undergraduate thesis students for the year; Autumn, Alon and Jacob. They’ll be subjected to the Phage Boot Camp, and be ready to tackle some exciting projects over the coming year. To learn more about them, check out their updated profiles on the “The Team” page.
Yesterday was Onam in Kerala… but more importantly (!), it was also Tamina’s wedding. I was honoured to be a part of such an important milestone in a love story that has spanned continents and weathered COVID - and delighted that we were able to take advantage of the occasion to get this, unusual, lab picture. I’m not sure we’ll ever top this one…
Congratulations Tamina & Johns!
Fresh news from Egypt, and the picture speaks for itself. Congratulations Amany!
It’s been almost exactly a year since we got everyone together (outside!) for a hike, and we were able to have a long overdue social today. Hiding behind us is a potluck including some remarkable fruits of a bake-off between Rabia and Felix, but ‘hiding’ in the foreground is the reason this was a particularly special gathering - the sashes on both Amany and Tamina! Big events in the coming months for both of them.
Yes, yes, I know the campy alliterations have got to go at some point, but this one was too easy. Today, Amany was awarded the Fred and Helen Knight Enrichment Award! She sent me the following emoji, which I am too old and uncool to decode, but I transpose it for you here:
In another alliterative headline, yesterday Rabia was recognized with a Thomas Neilson Scholarship, “Awarded to a Biochemistry graduate student deemed to show the greatest potential as an independent scientist at the time of transfer to the Ph.D. program”. And I couldn’t put it better myself. If the picture’s a little grainy, it’s because I cropped it from our lab social the other day… not exactly a wealth of picture to draw on this year!
Usually, on lab cleanup day I sing the praises of a cleanup, thank everyone for their hard work (and it is hard! There is scrubbing on hands and knees), and show a before-and-after pic - but today, the highlight is that between our two shifts, we managed to get almost everyone in the lab in one place and have lunch together.
Gayatri was just awarded a prestigious Farncombe Studentship to support her upcoming PhD start in the fall, extendible up to 3 years. She’s off to a flying start! I asked her for a recent picture, and she sent me this - in a coat. When the forecast for the next 4 days is above 30 degrees. I guess all of 2021 is ‘recent’.
With case numbers down below 1000/day, we re-opened the lab to limited (5 person) capacity - lifting a lockdown I had implemented to coincide with the provincial stay-at-home order. The team was definitely chomping at the bit to get back in the lab! Now to see if I can find us some filter tips….
In keeping with the alliterations of the last few updates, we’ve published a paper. This is the first research paper from the lab and to say I’m ecstatic would be an understatement. I won’t dig into the paper itself - I just want to highlight how critical the contributions of the authors was here. First, I did not think this was going to be our first paper - it wasn’t even on my radar when I came to McMaster - Rabia and Amany worked bloody hard to move this along quickly! Second, I was convinced we had to do short, 1.5-2 h assays to avoid confounding regrowth - it was thanks to Amany’s insistence and hard work that we wound up with the impressive eradication.
Al-Anany AM, Fatima R, Hynes AP. 2021. Temperate phage-antibiotic synergy eradicates bacteria through depletion of lysogens. Cell Reports 35(8):109172
Boy, there's a lot to celebrate this week - yet again! Wednesday and Thursday were the Faculty of Health Sciences Plenary, and Rabia, Janice, Amany and Tamina put together amazing talks in the restrictive Pecha Kucha format. I was blown away - I honestly thought we’d wind up with 2/3s of the finalists being from our lab! Amany's stellar performance was selected in the top 3, and she got to share a story that will be published later next week (more on that Tuesday the 25th!).
To top it off, Janice was awarded an Outstanding Achievement Award, Alejandra received the PDF Leadership Award. Wow.
It’s a delight to have former students keep me in the loop well after they leave the lab; this week we learned that Neeloufar was accepted to Medical School in Toronto, and that Hiba secured an extremely prestigious (seriously, I’m jealous - don’t look them up) Marie Skłodowska-Curie ESR fellowship to pursue a PhD at University College Cork, starting in September. Which is why the Shamrocks aren’t just a whimsical spring image.
As usual, I’m going to take partial credit for my student’s accomplishments, however unjust that may be.
I’ve recently been bemoaning the inability to adequately celebrate the many accomplishments of the lab and lab members. It turns out that, left to their own devices, the team can take care of themselves; see the celebratory cake. Today we’re celebrating Rabia’s NSERC-CGS-D - a major scholarship. Soon, soon my students won’t have to bake their own cakes.
The lab may be shut down for a(nother) stint, but there are still exciting developments to celebrate! Last week, Janice was awarded an NSERC CGS-M - fantastic! And when I asked her for a picture to use, she sent this one, and it hit me that as an undergraduate she had a ‘wall of dogs’ (pictures) in her room in residence, and as a graduate student, she’s had actual dogs. Clearly, graduate school is where dreams come true.
With the recent Stay-at-Home order in Ontario, I made the decision to shut down the lab for the next four weeks. If I said it was a difficult decision, I’d be lying - it’s a painful one, sure, but it was easy to make: things are getting bad out there.
My decision is no indictment of McMaster’s current research restrictions - every lab is different, and my comfort level with our shared space, location in the hospital, number of commuters on public transit, and other factors influenced my decision to impose restrictions beyond those in force on Campus.
We’ll see you all in four weeks. (Img: CBC, via PHO)
At this week’s McMaster Biochemistry Graduate Student Research Symposium (BBSRS), 5 of the team presented in some form or another - but the lab distinguished itself as both Alejandra and Janice won prizes for being best in their categories (oral PDF, Poster., respectively). The image below is a central panel in Janice’s poster - I learned from Michael Baym this week they were initially called “OMG” plates. Guess they still have that wow factor!
Last week, Tamina passed her Candidacy exam. Stressful at the best of times, I think it is even more stressful when you are being judged by 2-3 children under 6 as well as the usual panel of examiners. Well done, Tamina!
If the title catches your eye, hopefully our latest review will as well. Not only is it a great summary of where things are right now in the field, I think it also builds a strong case for how we could (and should) look at phages (even of aerobes) differently, and dig a little deeper to find the phages that lie just beyond the low-hanging fruit of the highly virulent phages.
Hiba did a fantastic job on this one, putting this all together mid-pandemic with a supervisor on parental leave.
We managed our annual secret santa despite the logistical challenges, and had an absoolute blast! In addition, I forced everyone to share what they were proud of in 2020, and it was a testimony to the team what a wonderful variety of personal milestones and accomplishments people had to look back on with pride.